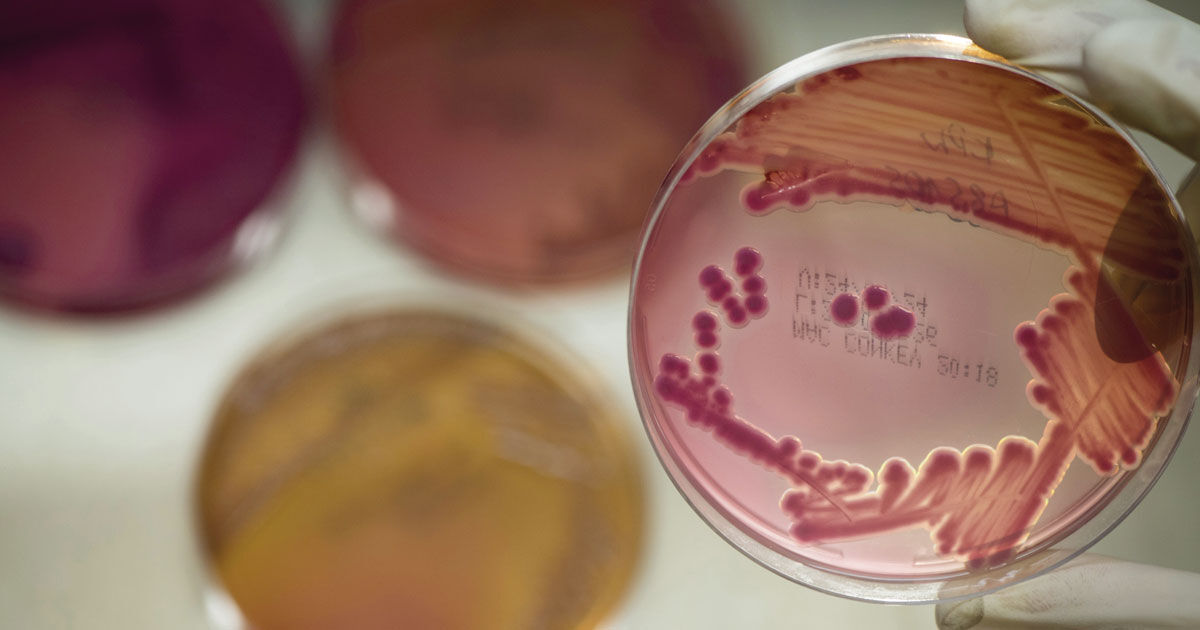
75ed20af3aff18603a68de7c29d829

マイストア
変更
お店で受け取る
(送料無料)
配送する
納期目安:
2026.04.04 5:17頃のお届け予定です。
決済方法が、クレジット、代金引換の場合に限ります。その他の決済方法の場合はこちらをご確認ください。
※土・日・祝日の注文の場合や在庫状況によって、商品のお届けにお時間をいただく場合がございます。
mape おまとめP. Bacteria (TC)【51】【41】【40】 Antibiotic-resistant bacteria could pose major health threatの詳細情報
Antibiotic-resistant bacteria could pose major health threat。A genome-wide atlas of antibiotic susceptibility targets and。Environmental Surveillance of Bacteria in a New Intensive Care。ご覧いただきありがとうございます。【発送について】冬季の発送は メルカリ便を予定しております。第四種郵便をご希望の場合は500円のお値引きを行なっておりますので購入前にお申し付けください。※ご購入後は変更出来ませんので必ず事前にお申し付けください。こちらの商品は 台湾のビカクシダ専門店より直接輸入した正規品ですので、安心してお迎えいただけます。ネームタグに関してはNyoqi Plantsのタグを同封させていただきます。育成の様子や植物の日常などはInstagram(ID: nyoqi_)でも発信しています。もし気になることがありましたら、そちらもあわせてご覧いただけると嬉しいです。誠実で丁寧なお取引を心がけております。植物は生き物であるため、プロフィールに記載しております注意点をご理解のうえご検討ください。『冬季の梱包方法について』冬の寒さが本格的になってきたため、“冬仕様の特別梱包” に変更いたしました。最後の写真をご覧下さい。植物が寒さでダメージを受けないよう、できる限り万全の状態で発送いたします。東北・北海道・寒冷地へお住まいの方へ最低気温が0℃を大きく下回る地域では、追加の対策が必要になる場合があります。。ビカクシダ P.Willinckii ‘Jade Girl’ Spore大きめ。ビカクシダ ウィリンキー 月光爪哇。ビカクシダ エルサ Elsa oc株 子株④。Brief antibiotic use drives human gut bacteria towards low-cost。P.Willinckii cv Mutant ウイリンキー選抜 変異個体希少株。ビカクシダ GINKA☓willinkiiDwarf 選抜 残り1点。ビカクシダ ハクナマタタ ocPUP 1株のみ。ビカクシダP.Emma, P.Blue monkey mix spore。k*i様 ビカクシダ ウィリンキー ジェイドガール。P.willinckii OMG sporeling ビカクシダ 板付。ビカクシダ P. 'Hakuna Matata' F301 OC 子株。Platycerium celso original ビカクシダ。Yellow moon dwarf ’totoro’ sporeling 510。極大サイズ ビカクシダP.willinckii 'Bacteria' spore。極大サイズ&超美品 ビカクシダ P.willinckii Jewel spore。ビカクシダ willinckii Golden Boy sporeling 金童。kazuさん専用、花芽付き、キンリョウヘン原種2鉢と日本蜜蜂の蜜蝋のセットです。そのため、ご購入前に一度ご連絡いただけると助かります。【同梱について】・同梱をご希望の場合は【まとめて取引】をご利用ください。点数により下記のサービスを行います!!・2点おまとめ購入の場合、¥500引き・3点おまとめ購入の場合、¥1000引きおまとめ購入をご検討よろしくお願い致します。
ベストセラーランキングです
近くの売り場の商品
カスタマーレビュー
オススメ度 4.5点
現在、3685件のレビューが投稿されています。